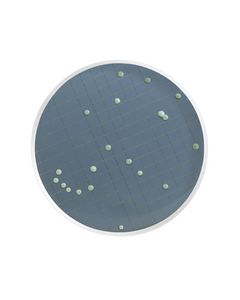
MHA000P2N.jpg

The store will not work correctly when cookies are disabled.
- Termos de pesquisa relacionados
-
millipore
-
filtracao polissulfona nalgene 47mm
-
filtracao polissulfon nalgene 47mm
-
filtracao polisulfon nalgene 47mm
-
filtracao polisulfona nalgene 47mm

PLACA PETRI TIPO LAMINA 47MM BASE RETANGULAR PETRISLIDE MILLIPORE (EMB. 100 UNID)
Modelo: PD1504700
R$ 984,08

HOLDER DIAM 47 mm EM POLISULFONA STERIFIL 500ml (S/ FRASCO COLETOR) MILLIPORE
Modelo: XX11J4750
R$ 1.503,61

PRE-FILTRO MISTURA ESTER/POLIESTER RW06 DIAM. 90mm RETENCAO 0,5um (CX) MILLIPORE
Modelo: RW0609000
R$ 1.226,40

MEMBRANA FILTRANTE MISTURA ESTERES AA DIAM. 25mm PORO 0,8um MILLIPORE - 100 UND
Modelo: AABG02500
R$ 872,59

KIT DE PECAS P/ REPOSICAO SWINNEX 47mm (ANÉIS E CHAVES PLÁSTICAS) MILLIPORE
Modelo: SX00047RK
R$ 3.654,52

PRE-FILTRO POLIPROPILENO AN06 DIAM 47mm PORO 0,6um MILLIPORE (CX/100 UND)
Modelo: AN0604700
R$ 1.036,41

PRE-FILTRO POLIPROPILENO AN12 DIAM 47mm PORO 1,2um MILLIPORE (CX/100 UND)
Modelo: AN1204700
R$ 973,16

FILTRO TELA DE NYLON 30cm X 3m ABERTURA 11um HIDROFILICO (EMB) MILLIPORE
Modelo: NY1100010
R$ 4.686,15

FILTRO TELA DE NYLON 30cm x 3m ABERTURA 60um HIDROFILICO (CX) MILLIPORE
Modelo: NY6000010
R$ 4.768,03

MANIFOLD 1 POSIÇÃO EZ-FIT MILLIPORE - P/ TULIPA DE TAMPA DE BORRACHA
Modelo: EZFITH0LD1
R$ 13.203,25

MEMB. FILTRANTE POLICARBONATO ISOPORE DIAM. 37mm PORO 0,4um MILLIPORE (CX/100 UND)
Modelo: HTTP03700
R$ 1.055,41

MEIO WALLERSTEIN EM AMPOLA 2ml PARA BACTERIAS MOFOS E LEVEDURAS (CX) MILLIPORE
Modelo: MHA000P2N
R$ 1.292,92